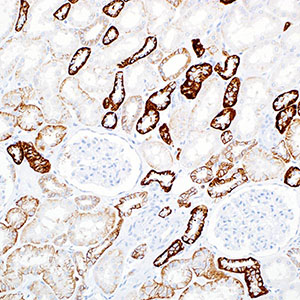
Ksp-Cadherin

Почечно-специфический кадгерин (Ksp-кадгерин или кадгерин-16) – представитель семейства кадгеринов, молекул клеточной адгезии, специфичный для почек. В почках Ksp-кадгерин обнаруживается исключительно в базолатеральной мембране клеток тубулярного эпителия и клеток собирательных трубочек и не обнаруживаются в клубочках, почечных интерстициальных клетках или сосудах. Недавние исследования показали, что антитела к Ksp-кадгерину могут быть использованы для того, чтобы отличить хромофобные почечные карциномы от онкоцитом: мембранное окрашивание наблюдается в 96% хромофобных карцином и только в 6% онкоцитом.
|
Купить Cell Marque Ksp-Cadherin, а также другие реактивы, антитела и системы детекции от лучших мировых производителей вы всегда сможете в нашей компании. |
![]() |
![]() |
![]() |
Наши преимущества:
Только качественные |
Минимально возможные |
Доставка по всей России с соблюдением температурного режима |
Полный пакет документов |
На данный момент мы сотрудничаем с ведущими зарубежными производителями лабораторных реактивов. Нашими клиентами являются как негосударственные, так и государственных учреждения, в том числе медицинские организации Москвы и других городов России. Для постоянных клиентов предусмотрена система скидок.